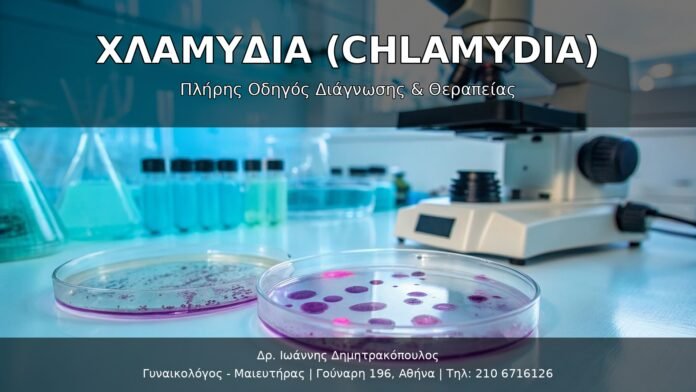

Εισαγωγή: Τι είναι η Χλαμύδια;
Η χλαμύδια (Chlamydia trachomatis) είναι μία από τις πιο κοινές σεξουαλικώς μεταδιδόμενες λοιμώξεις (STIs) παγκοσμίως. Σύμφωνα με τον Παγκόσμιο Οργανισμό Υγείας (WHO), εκτιμάται ότι πάνω από 130 εκατομμύρια νέες μολύνσεις συμβαίνουν κάθε χρόνο σε όλο τον κόσμο.
Παρά την υψηλή συχνότητα, η χλαμύδια παραμένει συχνά αθόρυβη (ασυμπτωματική) στο 70-80% των γυναικών και το 50% των ανδρών, γεγονός που την καθιστά ιδιαίτερα επικίνδυνη. Χωρίς έγκαιρη διάγνωση και θεραπεία, η χλαμύδια μπορεί να προκαλέσει σοβαρές επιπλοκές όπως:
- Πυελική Φλεγμονώδης Νόσος (PID) στις γυναίκες
- Χρόνια πυελική άλγος
- Στειρότητα (άνδρες και γυναίκες)
- Έκτοπη κύηση (εξωμήτρια)
- Νεογνικές λοιμώξεις (πνευμονία, οφθαλμία νεογνού)
Γιατί είναι τόσο σημαντική η έγκαιρη διάγνωση;
Η χλαμύδια είναι εύκολα θεραπεύσιμη με ένα μόνο δόση αντιβιοτικών αν ανιχνευτεί έγκαιρα. Όμως, οι μακροχρόνιες επιπλοκές μπορεί να είναι μη αναστρέψιμες.
Τι είναι ο Μικροοργανισμός Chlamydia Trachomatis;
Η Chlamydia trachomatis είναι ένα υποχρεωτικά ενδοκυττάριο βακτήριο, που σημαίνει ότι δεν μπορεί να επιβιώσει και να αναπαραχθεί εκτός των κυττάρων του ξενιστή. Έχει έναν μοναδικό διφασικό κύκλο ζωής:
Κύκλος Ζωής της Χλαμύδιας
- Elementary Body (EB): Η μολυσματική μορφή που είναι μεταβολικά ανενεργή αλλά ανθεκτική στο εξωτερικό περιβάλλον. Προσκολλάται στα επιθηλιακά κύτταρα και εισέρχεται μέσω ενδοκυττώσεως.
- Reticulate Body (RB): Η μεταβολικά ενεργή μορφή που αναπαράγεται μέσα στο κύτταρο του ξενιστή. Μετά από 48-72 ώρες, τα RBs μετατρέπονται πίσω σε EBs.
- Απελευθέρωση: Το κύτταρο του ξενιστή λύεται και απελευθερώνει νέα EBs που μπορούν να μολύνουν νέα κύτταρα.
Τύποι Chlamydia Trachomatis
Υπάρχουν διαφορετικοί οροτύποι (serovars) του βακτηρίου:
- Οροτύποι D-K: Υπεύθυνοι για γεννητικές και ουρηθρικές λοιμώξεις (STIs)
- Οροτύποι L1-L3: Προκαλούν λεμφογογγυλιακό γρανύλωμα (LGV), μια πιο επιθετική μορφή
- Οροτύποι A-C: Υπεύθυνοι για το τράχωμα, μια οφθαλμική λοίμωξη (κυρίως σε αναπτυσσόμενες χώρες)
Μηχανισμός Μετάδοσης
Πώς Μεταδίδεται η Χλαμύδια;
Η χλαμύδια μεταδίδεται μέσω άμεσης επαφής με μολυσμένους βλεννογόνους. Οι κύριες οδοί μετάδοσης είναι:
1. Σεξουαλική Μετάδοση
- Κολπική επαφή: Η πιο συχνή οδός μετάδοσης
- Πρωκτική επαφή: Μολύνει το ορθό
- Στοματική επαφή: Λιγότερο συχνή αλλά δυνατή (προκαλεί φαρυγγική χλαμύδια)
- Χέρια-γεννητικά όργανα: Μεταφορά μολυσμένων εκκρίσεων
2. Κατακόρυφη Μετάδοση (Μητέρα σε Μωρό)
Κατά τον τοκετό, το νεογνό μπορεί να μολυνθεί καθώς περνά από τον γεννητικό πόρο μολυσμένης μητέρας, προκαλώντας:
- Νεογνική οφθαλμία (30-50% των εκτεθειμένων νεογνών)
- Νεογνική πνευμονία (10-20% των εκτεθειμένων νεογνών)
3. Μη Σεξουαλικές Οδοί (Σπάνιες)
- Κοινή χρήση σεξουαλικών παιχνιδιών χωρίς καθαρισμό
- Μολυσμένα χέρια που έρχονται σε επαφή με μάτια (προκαλεί οφθαλμική χλαμύδια)
Παράγοντες Κινδύνου
Ορισμένα άτομα έχουν αυξημένο κίνδυνο μόλυνσης από χλαμύδια:
| Κατηγορία Κινδύνου | Παράγοντες |
|---|---|
| Ηλικία | Νέες γυναίκες 15-24 ετών (75% των κρουσμάτων) |
| Σεξουαλική Συμπεριφορά | Πολλαπλοί σεξουαλικοί σύντροφοι, νέος σύντροφος τελευταίους 3 μήνες |
| Προστασία | Χωρίς χρήση προφυλακτικού |
| Ιστορικό STIs | Προηγούμενη λοίμωξη από χλαμύδια ή άλλη STI |
| Κοινωνικοοικονομικοί | Χαμηλό εισόδημα, περιορισμένη πρόσβαση σε υγειονομική περίθαλψη |
Σημείωση: Η χλαμύδια μπορεί να μολύνει οποιονδήποτε σεξουαλικά ενεργό άτομο, ανεξάρτητα από την ηλικία, το φύλο ή τον σεξουαλικό προσανατολισμό.
Κλινικά Συμπτώματα της Χλαμύδιας
Γιατί Ονομάζεται “Σιωπηλή Λοίμωξη”;
Η χλαμύδια έχει χαρακτηριστεί ως “σιωπηλή επιδημία” επειδή:
- 70-80% των γυναικών δεν έχουν συμπτώματα
- 50% των ανδρών είναι ασυμπτωματικοί
- Τα συμπτώματα, όταν εμφανίζονται, είναι συχνά ήπια και μη ειδικά
Συμπτώματα στις Γυναίκες
Γεννητική Χλαμύδια
Περίοδος Επώασης: 1-3 εβδομάδες μετά την έκθεση
Πρώιμα Συμπτώματα:
- Αυξημένες κολπικές εκκρίσεις: Μπορεί να είναι υδαρείς ή πυώδεις
- Δυσουρία: Πόνος ή κάψιμο κατά την ούρηση
- Ουρηθρίτιδα: Φλεγμονή της ουρήθρας
- Τραχηλίτιδα: Φλεγμονή του τραχήλου της μήτρας (πιο συχνό)
- Μετεμμηνορρυσική αιμορραγία: Ελαφριά αιμορραγία μετά τη σεξουαλική επαφή
- Κοιλιακό άλγος: Ήπιος πόνος στην κάτω κοιλία
Πυελική Φλεγμονώδης Νόσος (PID)
Αν η χλαμύδια δεν αντιμετωπιστεί, μπορεί να εξαπλωθεί προς τα πάνω στη μήτρα, τις σάλπιγγες και τις ωοθήκες, προκαλώντας PID. Συμπτώματα:
- Έντονος πυρετός (>38°C)
- Σοβαρό πυελικό άλγος
- Ναυτία και έμετος
- Πόνος κατά τη σεξουαλική επαφή (δυσπαρευνία)
- Μη φυσιολογικές αιμορραγίες
Επικίνδυνη Επιπλοκή: Το 10-15% των μη θεραπευμένων χλαμυδίων στις γυναίκες εξελίσσονται σε PID.
Συμπτώματα στους Άνδρες
Ουρηθρίτιδα
Περίοδος Επώασης: 1-3 εβδομάδες
Συμπτώματα:
- Ουρηθρική έκκριση: Συνήθως υδαρής ή βλεννώδης (όχι πυώδης όπως στη γονόρροια)
- Δυσουρία: Κάψιμο κατά την ούρηση
- Κνησμός στην ουρήθρα
- Πόνος στους όρχεις (ορχεπιδιδυμίτιδα)
Ορχεπιδιδυμίτιδα
Η χλαμύδια μπορεί να εξαπλωθεί στον επιδιδυμίδα (σωλήνας που μεταφέρει το σπέρμα από τους όρχεις). Συμπτώματα:
- Πόνος και οίδημα στους όρχεις
- Πυρετός
- Ερυθρότητα του οσχέου
Συμπτώματα σε Άλλες Περιοχές
Πρωκτική Χλαμύδια
- Συχνά ασυμπτωματική
- Πρωκτικό άλγος και δυσφορία
- Απορροές από τον πρωκτό
- Αιμορραγία από τον πρωκτό
- Τενεσμός (αίσθημα ημιτελούς κένωσης)
Φαρυγγική Χλαμύδια
- Σχεδόν πάντα ασυμπτωματική
- Σπάνια προκαλεί φαρυγγίτιδα ή πονόλαιμο
Οφθαλμική Χλαμύδια
- Επιπεφυκίτιδα (φλεγμονή του επιπεφυκότα)
- Ερυθρότητα και πόνος στο μάτι
- Έκκριση από το μάτι
- Φωτοφοβία
Επιπλοκές της Χλαμύδιας
Μακροχρόνιες Επιπλοκές στις Γυναίκες
1. Πυελική Φλεγμονώδης Νόσος (PID)
Η PID είναι η πιο σοβαρή επιπλοκή της χλαμύδιας στις γυναίκες:
- Επίπτωση: 10-15% των μη θεραπευμένων κρουσμάτων
- Συνέπειες:
- Χρόνιο πυελικό άλγος (20-30%)
- Στειρότητα από απόφραξη των σαλπίγγων (20%)
- Έκτοπη κύηση (10 φορές υψηλότερος κίνδυνος)
2. Στειρότητα
Η χλαμύδια είναι μία από τις κύριες αιτίες γυναικείας στειρότητας:
- Μηχανισμός: Η χρόνια φλεγμονή προκαλεί ουλές και απόφραξη των σαλπίγγων
- Κίνδυνος: Αυξάνεται με κάθε επεισόδιο PID:
- Μετά από 1 επεισόδιο: 10-15%
- Μετά από 2 επεισόδια: 25-35%
- Μετά από 3+ επεισόδια: 50-75%
3. Έκτοπη Κύηση (Εξωμήτρια)
- Όταν οι σάλπιγγες είναι μερικώς αποφραγμένες, το γονιμοποιημένο ωάριο μπορεί να εμφυτευτεί στη σάλπιγγα αντί για τη μήτρα
- Κίνδυνος: 10 φορές υψηλότερος σε γυναίκες με ιστορικό PID
- Συνέπειες: Απειλητική για τη ζωή αιμορραγία αν η σάλπιγγα ραγεί
4. Χρόνιο Πυελικό Άλγος
- Επίμονος πόνος που διαρκεί >6 μήνες
- Επηρεάζει την ποιότητα ζωής και τη σεξουαλική υγεία
Επιπλοκές στους Άνδρες
1. Ορχεπιδιδυμίτιδα
- Συχνότητα: 1-3% των μη θεραπευμένων ανδρών
- Επιπλοκές:
- Χρόνιος πόνος στους όρχεις
- Μείωση της γονιμότητας (σε σοβαρές περιπτώσεις)
2. Στειρότητα
- Σπανιότερη από τη γυναικεία, αλλά δυνατή
- Μηχανισμός: Απόφραξη των σπερματικών πόρων από ουλές
Επιπλοκές κατά την Εγκυμοσύνη
Μητρικές Επιπλοκές
- Πρόωρος τοκετός
- Πρόωρη ρήξη των υμένων
- Μετατοκετική ενδομητρίτιδα
Νεογνικές Επιπλοκές
1. Νεογνική Οφθαλμία (Ophthalmia Neonatorum)
- Επίπτωση: 30-50% των εκτεθειμένων νεογνών
- Εμφάνιση: 5-14 ημέρες μετά τον τοκετό
- Συμπτώματα: Πόνος, οίδημα, έκκριση από τα μάτια
- Θεραπεία: Συστημικά αντιβιοτικά (ερυθρομυκίνη)
2. Νεογνική Πνευμονία
- Επίπτωση: 10-20% των εκτεθειμένων νεογνών
- Εμφάνιση: 1-3 μήνες μετά τη γέννηση
- Συμπτώματα: Βήχας, ταχύπνοια, χαμηλός πυρετός
- Θεραπεία: Ερυθρομυκίνη για 14 ημέρες
Άλλες Επιπλοκές
Σύνδρομο Reiter (Αντιδραστική Αρθρίτιδα)
Σπάνια αυτοάνοση επιπλοκή που εμφανίζεται μετά από λοίμωξη χλαμύδιας:
- Συμπτώματα: Αρθρίτιδα, ουρηθρίτιδα, επιπεφυκίτιδα
- Κίνδυνος: Υψηλότερος σε άτομα με γενετική προδιάθεση (HLA-B27)
Διάγνωση της Χλαμύδιας
Γιατί είναι Σημαντική η Τακτική Εξέταση;
Λόγω της υψηλής επίπτωσης ασυμπτωματικών κρουσμάτων, οι ιατρικοί οργανισμοί συνιστούν τακτικό screening για:
- Όλες τις σεξουαλικά ενεργές γυναίκες <25 ετών (ετησίως)
- Γυναίκες >25 ετών με παράγοντες κινδύνου (πολλαπλοί σύντροφοι, νέος σύντροφος)
- Έγκυες γυναίκες (στην πρώτη προγεννητική επίσκεψη και στο 3ο τρίμηνο για υψηλού κινδύνου)
- Άνδρες που έχουν σεξ με άνδρες (MSM)
- Άτομα με νέο σεξουαλικό σύντροφο
Μέθοδοι Διάγνωσης
1. Μοριακές Μέθοδοι (NAAT – Nucleic Acid Amplification Tests)
Αυτές είναι οι πιο ευαίσθητες και ειδικές μέθοδοι διάγνωσης:
| Τύπος NAAT | Ευαισθησία | Ειδικότητα | Χαρακτηριστικά |
|---|---|---|---|
| PCR (Polymerase Chain Reaction) | 90-95% | 99% | Χρυσός κανόνας διάγνωσης |
| TMA (Transcription-Mediated Amplification) | 90-95% | 99% | Ανιχνεύει RNA αντί για DNA |
| SDA (Strand Displacement Amplification) | 85-90% | 98% | Γρηγορότερη από PCR |
Τύποι Δειγμάτων για NAAT:
- Γυναίκες:
- Κολπικό swap (αυτό-συλλογή ή από γιατρό)
- Πρώτο πρωινό ούρο (15-30 ml)
- Τραχηλικό swap
- Άνδρες:
- Πρώτο πρωινό ούρο (προτιμότερο)
- Ουρηθρικό swap
- Πρωκτική χλαμύδια: Πρωκτικό swap
- Φαρυγγική χλαμύδια: Φαρυγγικό swap
Πλεονεκτήματα NAAT:
✅ Υψηλή ευαισθησία και ειδικότητα
✅ Δυνατότητα αυτό-συλλογής δείγματος (ούρα ή κολπικό swap)
✅ Ταχύτερα αποτελέσματα (24-48 ώρες)
2. Καλλιέργεια Κυττάρων
Παλαιότερη μέθοδος που σπάνια χρησιμοποιείται πλέον:
- Ευαισθησία: 70-85% (χαμηλότερη από NAAT)
- Πλεονεκτήματα:
- Επιτρέπει δοκιμές αντοχής στα αντιβιοτικά
- Χρήσιμη σε νομικές περιπτώσεις (π.χ. σεξουαλική κακοποίηση)
- Μειονεκτήματα:
- Απαιτεί ειδικές συνθήκες μεταφοράς
- Αργά αποτελέσματα (3-7 ημέρες)
- Πιο δαπανηρή
3. Ορολογικές Εξετάσεις (Αντισώματα)
Ανίχνευση αντισωμάτων IgG και IgM στο αίμα:
- Δεν χρησιμοποιείται για οξεία διάγνωση (δεν διακρίνει παλιά από ενεργή λοίμωξη)
- Χρήσιμη για:
- Διερεύνηση PID
- Διερεύνηση στειρότητας
- Επιδημιολογικές μελέτες
4. Άλλες Εξετάσεις
- Ανοσοφθορισμός (DFA – Direct Fluorescent Antibody): Χαμηλότερη ευαισθησία (60-80%)
- Enzyme Immunoassay (EIA): Επίσης χαμηλότερη ευαισθησία
Πότε Πρέπει να Κάνετε Εξέταση;
Κάντε εξέταση για χλαμύδια αν:
- Έχετε συμπτώματα (ακόμα και ήπια)
- Ο σύντροφός σας διαγνώστηκε με χλαμύδια
- Είστε σεξουαλικά ενεργός <25 ετών (ετήσιο screening)
- Έχετε νέο σεξουαλικό σύντροφο
- Έχετε πολλαπλούς συντρόφους
- Είστε έγκυος
- Έχετε ιστορικό άλλης STI
Θεραπεία της Χλαμύδιας
Γενικές Αρχές Θεραπείας
Η χλαμύδια είναι εύκολα θεραπεύσιμη με αντιβιοτικά. Οι στόχοι της θεραπείας είναι:
- Εξάλειψη της λοίμωξης
- Πρόληψη επιπλοκών
- Μείωση της μετάδοσης
Θεραπεία Πρώτης Γραμμής
1. Αζιθρομυκίνη (Azithromycin)
| Παράμετρος | Λεπτομέρειες |
|---|---|
| Δοσολογία | 1 γραμμάριο (1000 mg) μονή δόση από του στόματος |
| Αποτελεσματικότητα | 97-98% ποσοστό θεραπείας |
| Πλεονεκτήματα | Μονή δόση → καλύτερη συμμόρφωση |
| Παρενέργειες | Ναυτία, διάρροια, κοιλιακό άλγος (10-15%) |
2. Δοξυκυκλίνη (Doxycycline)
| Παράμετρος | Λεπτομέρειες |
|---|---|
| Δοσολογία | 100 mg δύο φορές την ημέρα για 7 ημέρες |
| Αποτελεσματικότητα | 98-99% ποσοστό θεραπείας |
| Πλεονεκτήματα | Ελαφρώς υψηλότερη αποτελεσματικότητα, χαμηλότερο κόστος |
| Μειονεκτήματα | Απαιτεί πολλαπλές δόσεις → χειρότερη συμμόρφωση |
| Παρενέργειες | Φωτοευαισθησία, γαστρεντερικά συμπτώματα |
| Αντενδείξεις | Εγκυμοσύνη, ηλικία <8 ετών |
Ποια είναι η καλύτερη επιλογή;
– Αζιθρομυκίνη: Προτιμάται για καλύτερη συμμόρφωση (μονή δόση)
– Δοξυκυκλίνη: Ελαφρώς πιο αποτελεσματική, αλλά απαιτεί 7 ημέρες
Εναλλακτικές Θεραπείες
Αν η αζιθρομυκίνη ή η δοξυκυκλίνη δεν είναι κατάλληλες:
| Αντιβιοτικό | Δοσολογία | Διάρκεια | Σημειώσεις |
|---|---|---|---|
| Λεβοφλοξασίνη (Levofloxacin) | 500 mg/ημέρα | 7 ημέρες | Αποτελεσματική, αλλά πιο δαπανηρή |
| Οφλοξασίνη (Ofloxacin) | 300 mg 2x/ημέρα | 7 ημέρες | Εναλλακτική των φθοριοκινολονών |
| Ερυθρομυκίνη (Erythromycin) | 500 mg 4x/ημέρα | 7 ημέρες | Ασφαλής σε εγκυμοσύνη |
Θεραπεία σε Ειδικές Καταστάσεις
Θεραπεία κατά την Εγκυμοσύνη
Συνιστώμενες επιλογές:
- Αζιθρομυκίνη: 1 γραμμάριο μονή δόση (προτιμότερη)
- Αμοξυκιλλίνη: 500 mg τρεις φορές την ημέρα για 7 ημέρες
- Ερυθρομυκίνη: 500 mg τέσσερις φορές την ημέρα για 7 ημέρες
Αντενδείξεις:
- Δοξυκυκλίνη (ΟΧΙ σε εγκυμοσύνη – προκαλεί αποχρωματισμό δοντιών)
- Φθοριοκινολόνες (ΟΧΙ σε εγκυμοσύνη)
Επανεξέταση: 3 εβδομάδες μετά την ολοκλήρωση της θεραπείας (Test of Cure)
Θεραπεία Πυελικής Φλεγμονώδους Νόσου (PID)
Ήπια-Μέτρια PID (εξωνοσοκομειακή):
- Κεφτριαξόνη 500 mg IM μονή δόση
+ Δοξυκυκλίνη 100 mg 2x/ημέρα για 14 ημέρες
± Μετρονιδαζόλη 500 mg 2x/ημέρα για 14 ημέρες (αν υπάρχει υποψία αναερόβιας λοίμωξης)
Σοβαρή PID (νοσοκομειακή):
- Ενδοφλέβια αντιβιοτικά (κεφαλοσπορίνες + δοξυκυκλίνη + μετρονιδαζόλη)
Θεραπεία Νεογνικής Χλαμύδιας
Νεογνική Οφθαλμία:
- Ερυθρομυκίνη 12.5 mg/kg 4 φορές την ημέρα για 14 ημέρες (από του στόματος)
Νεογνική Πνευμονία:
- Ερυθρομυκίνη 12.5 mg/kg 4 φορές την ημέρα για 14 ημέρες
Οδηγίες μετά τη Θεραπεία
Αποχή από Σεξουαλική Δραστηριότητα
- Αζιθρομυκίνη: Αποχή για 7 ημέρες μετά τη λήψη της δόσης
- Δοξυκυκλίνη: Αποχή για ολόκληρη τη διάρκεια της θεραπείας και 7 ημέρες μετά
Θεραπεία των Συντρόφων
Expedited Partner Therapy (EPT):
- Ο γιατρός μπορεί να συνταγογραφήσει αντιβιοτικά και για τον σύντροφο χωρίς να τον εξετάσει
- Ο σύντροφος πρέπει να λάβει θεραπεία ταυτόχρονα για να αποφευχθεί η επαναμόλυνση
Test of Cure (Επανεξέταση)
Δεν απαιτείται σε περισσότερες περιπτώσεις, εκτός αν:
- Η ασθενής είναι έγκυος (επανεξέταση σε 3 εβδομάδες)
- Τα συμπτώματα επιμένουν μετά τη θεραπεία
- Υπάρχει αμφιβολία για τη συμμόρφωση
Repeat Testing (Επανεξέταση για Επαναμόλυνση):
- Συνιστάται σε 3 μήνες για όλους τους ασθενείς
- Κίνδυνος επαναμόλυνσης: 10-20% εντός 6 μηνών
Αντοχή στα Αντιβιοτικά
Η αντοχή της χλαμύδιας στα αντιβιοτικά είναι σπάνια αλλά αναφέρεται:
- Αζιθρομυκίνη: Σπάνια αντοχή, αλλά αναφέρονται μερικές περιπτώσεις
- Δοξυκυκλίνη: Πολύ σπάνια αντοχή
Αν η θεραπεία αποτύχει:
1. Επιβεβαιώστε τη διάγνωση με επανεξέταση
2. Ελέγξτε για επαναμόλυνση (μη θεραπευμένος σύντροφος)
3. Ελέγξτε για άλλες STIs (συνύπαρξη γονόρροιας)
4. Εξετάστε εναλλακτικά αντιβιοτικά
Πρόληψη της Χλαμύδιας
Πρωτογενής Πρόληψη
1. Χρήση Προφυλακτικού
Η σωστή και συνεπής χρήση προφυλακτικού είναι ο πιο αποτελεσματικός τρόπος πρόληψης:
- Αποτελεσματικότητα: Μειώνει τον κίνδυνο κατά 80-95%
- Τύποι:
- Ανδρικό προφυλακτικό (λάτεξ ή πολυουρεθάνης): Πιο αποτελεσματικό
- Γυναικείο προφυλακτικό: Λιγότερο αποτελεσματικό αλλά καλύτερο από τίποτα
Συμβουλές για σωστή χρήση:
- Χρησιμοποιείτε νέο προφυλακτικό σε κάθε σεξουαλική πράξη
- Φυλάξτε τα προφυλακτικά σε δροσερό και στεγνό μέρος
- Ελέγξτε την ημερομηνία λήξης
- Μη χρησιμοποιείτε λιπαντικά με βάση το λάδι (καταστρέφουν το λάτεξ)
2. Μονογαμική Σχέση
- Μια μακροχρόνια, αμοιβαία μονογαμική σχέση με σύντροφο που έχει ελεγχθεί και είναι αρνητικός
3. Μείωση Αριθμού Συντρόφων
- Όσο λιγότεροι σεξουαλικοί σύντροφοι, τόσο μικρότερος ο κίνδυνος
4. Αποχή από Σεξουαλική Δραστηριότητα
- Η μόνη 100% αποτελεσματική μέθοδος
Δευτερογενής Πρόληψη (Screening)
Συνιστώμενα Screening Προγράμματα
Γυναίκες:
- Ηλικία <25 ετών: Ετήσιο screening αν σεξουαλικά ενεργές
- Ηλικία ≥25 ετών: Screening αν υπάρχουν παράγοντες κινδύνου
- Έγκυες: Screening στην πρώτη προγεννητική επίσκεψη και στο 3ο τρίμηνο
Άνδρες:
- MSM (άνδρες που έχουν σεξ με άνδρες): Ετήσιο screening, ή κάθε 3-6 μήνες αν υψηλός κίνδυνος
- Ετερόφυλοι άνδρες: Screening μόνο αν υπάρχουν συμπτώματα ή υψηλός κίνδυνος
Τριτογενής Πρόληψη (Πρόληψη Επιπλοκών)
- Έγκαιρη θεραπεία για πρόληψη PID, στειρότητας, έκτοπης κύησης
- Θεραπεία συντρόφων για πρόληψη επαναμόλυνσης
- Επανεξέταση σε 3 μήνες για ανίχνευση επαναμόλυνσης
Pre-Exposure Prophylaxis (PrEP) – Υπό Διερεύνηση
Σε αντίθεση με το HIV, δεν υπάρχει εγκεκριμένη PrEP για τη χλαμύδια. Ωστόσο, μελέτες εξετάζουν:
- Δοξυκυκλίνη Post-Exposure Prophylaxis (Doxy-PEP): Λήψη δοξυκυκλίνης εντός 72 ωρών μετά τη σεξουαλική έκθεση
- Μελέτες δείχνουν μείωση του κινδύνου κατά 60-70%
- Ακόμα δεν είναι εγκεκριμένη πρακτική
Εκπαίδευση και Ενημέρωση
- Σεξουαλική διαπαιδαγώγηση για νέους
- Ενημέρωση για τους κινδύνους των STIs
- Ανοιχτή συζήτηση με τον σύντροφο για σεξουαλική υγεία
Συχνές Ερωτήσεις (FAQ)
1. Μπορώ να μολυνθώ ξανά με χλαμύδια μετά τη θεραπεία;
Ναι. Η θεραπεία της χλαμύδιας δεν παρέχει ανοσία. Μπορείτε να μολυνθείτε ξανά αν έρθετε σε επαφή με τον ίδιο ή διαφορετικό μολυσμένο σύντροφο. Το 10-20% των ατόμων επαναμολύνονται εντός 6 μηνών.
2. Πόσο σύντομα μπορώ να κάνω τεστ μετά την έκθεση;
Η περίοδος επώασης της χλαμύδιας είναι 1-3 εβδομάδες. Για ακριβή αποτελέσματα, κάντε τεστ τουλάχιστον 2 εβδομάδες μετά την έκθεση. Αν το τεστ είναι αρνητικό, επαναλάβετε το σε 4-6 εβδομάδες.
3. Μπορώ να μολυνθώ από τουαλέτα ή πισίνα;
Όχι. Η χλαμύδια δεν επιβιώνει εκτός του ανθρώπινου σώματος. Μεταδίδεται μόνο μέσω άμεσης σεξουαλικής επαφής ή κατά τον τοκετό.
4. Αν δεν έχω συμπτώματα, χρειάζομαι θεραπεία;
Ναι, απαραίτητα! Ακόμα και αν δεν έχετε συμπτώματα, η χλαμύδια μπορεί να προκαλέσει σοβαρές μακροχρόνιες επιπλοκές (PID, στειρότητα). Επιπλέον, μπορείτε να μολύνετε τους συντρόφους σας.
5. Μπορεί η χλαμύδια να εξαφανιστεί μόνη της;
Όχι. Η χλαμύδια δεν εξαφανίζεται χωρίς αντιβιοτική θεραπεία. Χωρίς θεραπεία, μπορεί να παραμείνει στο σώμα για χρόνια και να προκαλέσει σοβαρές επιπλοκές.
6. Η χλαμύδια επηρεάζει την εγκυμοσύνη;
Ναι. Η μη θεραπευμένη χλαμύδια κατά την εγκυμοσύνη μπορεί να προκαλέσει πρόωρο τοκετό, πρόωρη ρήξη των υμένων και νεογνικές λοιμώξεις (οφθαλμία, πνευμονία). Επίσης, η χρόνια χλαμύδια μπορεί να προκαλέσει στειρότητα.
7. Πώς μπορώ να πω στον σύντροφό μου ότι έχω χλαμύδια;
Είναι σημαντικό να ενημερώσετε τον σύντροφό σας αμέσως για να λάβει θεραπεία και να αποφευχθεί η επαναμόλυνση. Μπορείτε:
- Να μιλήσετε ανοιχτά και ήρεμα
- Να τονίσετε ότι η χλαμύδια είναι κοινή και εύκολα θεραπεύσιμη
- Να προτείνετε ταυτόχρονη θεραπεία
- Αν δυσκολεύεστε, ο γιατρός σας μπορεί να βοηθήσει (ανώνυμες υπηρεσίες ειδοποίησης)
8. Μπορώ να πάρω χλαμύδια από στοματικό σεξ;
Ναι. Αν και λιγότερο συχνό, το στοματικό σεξ μπορεί να μεταδώσει χλαμύδια στο φάρυγγα. Η φαρυγγική χλαμύδια είναι συχνά ασυμπτωματική αλλά μπορεί να μεταδοθεί σε συντρόφους.
9. Πόσο καιρό μετά τη θεραπεία μπορώ να κάνω σεξ;
Πρέπει να αποφύγετε τη σεξουαλική επαφή για 7 ημέρες μετά τη λήψη της θεραπείας (για μονή δόση αζιθρομυκίνης) ή μέχρι να ολοκληρωθεί η θεραπεία και 7 ημέρες μετά (για δοξυκυκλίνη). Επίσης, βεβαιωθείτε ότι ο σύντροφός σας έχει λάβει επίσης θεραπεία.
10. Αν είμαι θετικός στη χλαμύδια, πρέπει να ελεγχθώ για άλλες STIs;
Ναι, συνιστάται ανεπιφύλακτα. Τα άτομα με χλαμύδια έχουν αυξημένο κίνδυνο για άλλες STIs, ιδίως:
- Γονόρροια (συχνά συνυπάρχει με χλαμύδια)
- HIV
- Σύφιλη
- Ηπατίτιδα B και C
Κοινωνικά και Ψυχολογικά Θέματα
Στιγματισμός και STIs
Δυστυχώς, οι STIs συχνά συνδέονται με στιγματισμό και ντροπή, γεγονός που μπορεί να εμποδίσει τα άτομα να ζητήσουν βοήθεια. Είναι σημαντικό να κατανοήσουμε:
- Η χλαμύδια είναι μια ιατρική κατάσταση, όχι ηθικό πρόβλημα
- Είναι πολύ κοινή και μπορεί να συμβεί σε οποιονδήποτε
- Η έγκαιρη διάγνωση και θεραπεία είναι πράξη υπευθυνότητας
Επικοινωνία με τον Σύντροφο
Η ειλικρινής επικοινωνία για τη σεξουαλική υγεία είναι ζωτικής σημασίας:
- Συζητήστε το ιστορικό STIs με νέους συντρόφους
- Κάντε τεστ μαζί πριν από την έναρξη μιας νέας σχέσης
- Ενημερώστε τους συντρόφους αν διαγνωστείτε με χλαμύδια
Πρόσβαση σε Υπηρεσίες Υγείας
- Αναζητήστε εμπιστευτικές υπηρεσίες αν ανησυχείτε για την ιδιωτικότητα
- Πολλές κλινικές προσφέρουν δωρεάν ή χαμηλού κόστους εξετάσεις
- Χρησιμοποιήστε τηλεϊατρική αν δυσκολεύεστε να επισκεφθείτε γιατρό
Πότε Πρέπει να Επισκεφθείτε Γιατρό
Επισκεφθείτε αμέσως γυναικολόγο ή δερματολόγο-αφροδισιολόγο αν:
- Έχετε οποιαδήποτε συμπτώματα STI (έκκριση, δυσουρία, πυελικό άλγος)
- Ο σύντροφός σας διαγνώστηκε με χλαμύδια
- Είστε σεξουαλικά ενεργός <25 ετών και δεν έχετε κάνει τεστ τον τελευταίο χρόνο
- Έχετε νέο σεξουαλικό σύντροφο ή πολλαπλούς συντρόφους
- Είστε έγκυος ή σχεδιάζετε εγκυμοσύνη
- Έχετε ιστορικό άλλης STI
Συμπέρασμα
Η χλαμύδια είναι η πιο κοινή βακτηριακή σεξουαλικώς μεταδιδόμενη λοίμωξη παγκοσμίως. Παρόλο που είναι συχνά ασυμπτωματική, μπορεί να προκαλέσει σοβαρές και μόνιμες επιπλοκές, ιδίως στις γυναίκες, συμπεριλαμβανομένης της στειρότητας, της πυελικής φλεγμονώδους νόσου και της έκτοπης κύησης.
Τα κλειδιά για την αντιμετώπιση της χλαμύδιας είναι:
- Πρόληψη: Χρήση προφυλακτικού, μείωση αριθμού συντρόφων, ανοιχτή επικοινωνία
- Έγκαιρη Διάγνωση: Τακτικό screening, ειδικά για νέες γυναίκες <25 ετών
- Αποτελεσματική Θεραπεία: Εύκολα θεραπεύσιμη με μια μονή δόση αντιβιοτικών
- Θεραπεία Συντρόφων: Ταυτόχρονη θεραπεία για πρόληψη επαναμόλυνσης
- Επανεξέταση: Σε 3 μήνες για ανίχνευση επαναμόλυνσης
Μήνυμα προς όλους: Η χλαμύδια δεν είναι πηγή ντροπής. Είναι μια κοινή λοίμωξη που επηρεάζει εκατομμύρια ανθρώπους κάθε χρόνο. Με την έγκαιρη διάγνωση και θεραπεία, μπορεί να θεραπευτεί εντελώς χωρίς μακροχρόνιες επιπλοκές. Φροντίστε τη σεξουαλική σας υγεία με υπευθυνότητα!
Πληροφορίες Επικοινωνίας
Δρ. Ιωάννης Δημητρακόπουλος
Γυναικολόγος – Μαιευτήρας – Χειρουργός
Γούναρη 196, Γλυφάδα, Αθήνα 16674
📞 Τηλέφωνο: 210 6716126
📧 Email: info@dr-dimitrakopoulos.com
🌐 Website: https://dr-dimitrakopoulos.com
Για ραντεβού ή περισσότερες πληροφορίες σχετικά με τη χλαμύδια και άλλες σεξουαλικώς μεταδιδόμενες λοιμώξεις, μην διστάσετε να επικοινωνήσετε.
Οι πληροφορίες σε αυτό το άρθρο είναι ενημερωτικές και δεν αντικαθιστούν την ιατρική συμβουλή. Συμβουλευτείτε πάντα έναν επαγγελματία υγείας για προσωπική διάγνωση και θεραπεία.
Ιωάννης Κ. Δημητρακόπουλος
Μαιευτήρας - Χειρουργός - Γυναικολόγος
Μάστερ Αισθητικής Ιατρικής - Αναίμακτης Αισθητικής Γυναικολογίας - Αναγεννητικής Ιατρικής και Αναίμακτης Χειρουργικής
Τηλ.: 210 6716126 Κιν.: 6985 64 64 10 e-mail ikdmd@hotmail.com
Ιατρείο: Λεωφ. Δημητρίου Γούναρη 196 Γλυφάδα Τ.Κ. 166 74
Εξατομικευμένη εφαρμογή πρωτοποριακών ιατρικών τεχνικών στην υπηρεσία της σύγχρονης γυναίκας.
Γυναικολογία - Μαιευτική - Εξατομικευμένη Διερεύνηση και Αντιμετώπιση Ανδρικής και Γυναικείας Υπογονιμότητας - Υποβοηθούμενη Αναπαραγωγή -Επιγενετική - Εφαρμοσμένη Γυναικολογική Βιοχημεία – Ενδοκρινολογία - Μικροθρεπτική και Ιατρική Διατροφή στην Κύηση, την Υπογονιμότητα και τη Γυναικολογία - Συνεργάτης Μαιευτηρίων "Μητέρα" και "Λητώ" -
Μέλος της Εταιρίας Αισθητικής Ιατρικής και Αναίμακτης Χειρουργικής (SAMNAS)